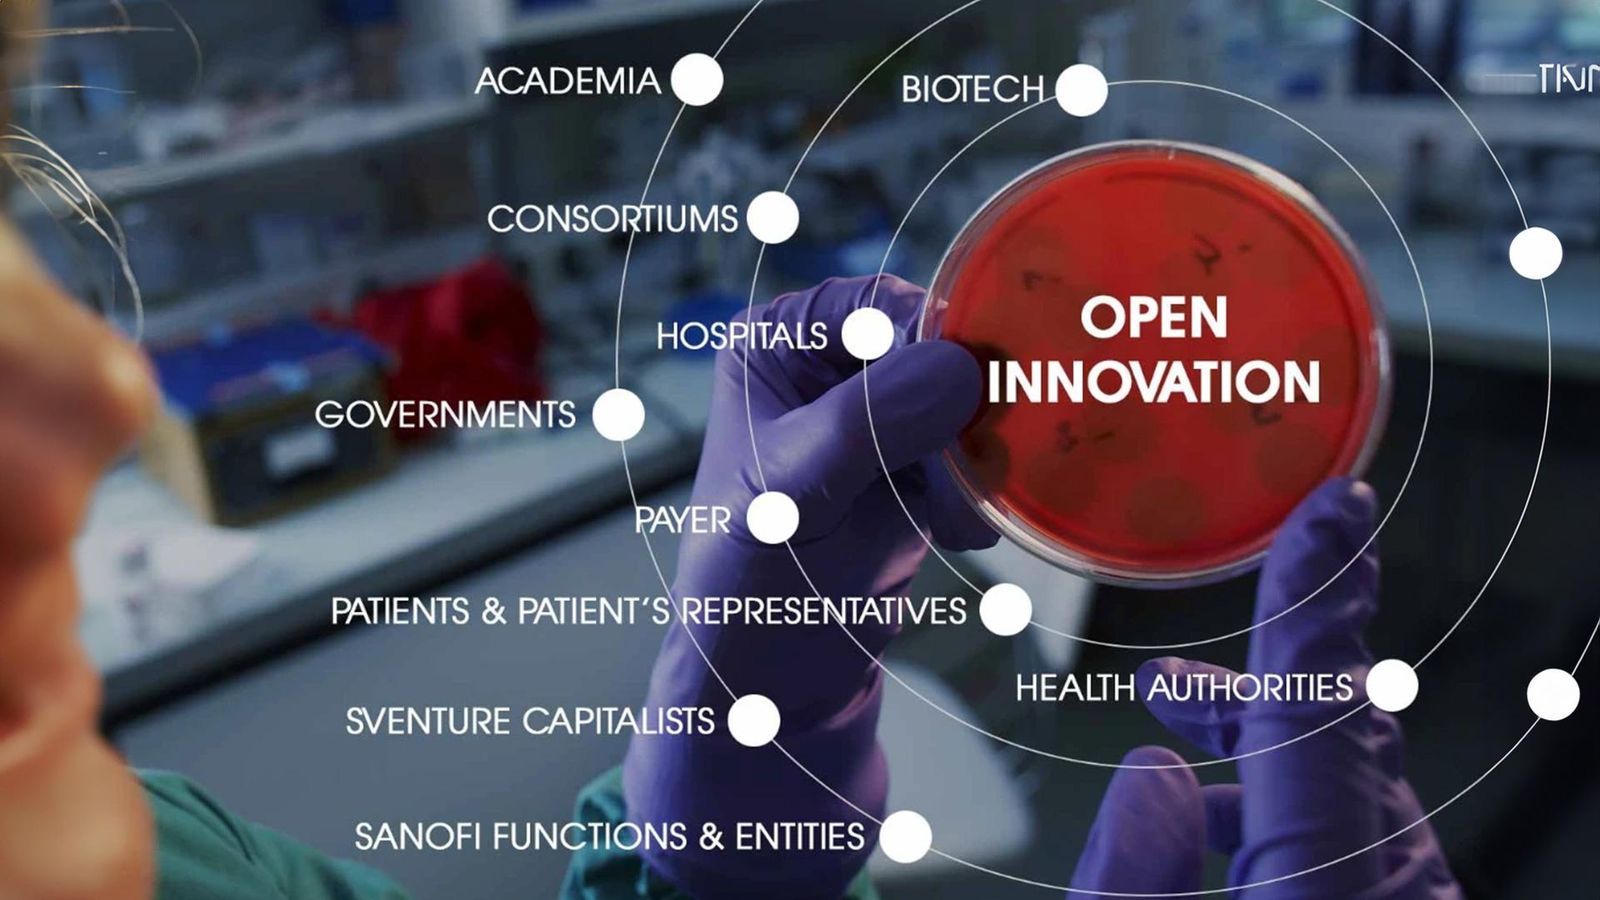

Open innovation is a strategy to improve R&D efficiency through collaborative research and development with various partners, such as external academia, government, and industry, rather than closed R&D, where all research and development is conducted within a company. It is becoming an essential survival strategy for pharmaceutical companies in the face of declining R&D productivity, increasing socioeconomic burden on healthcare expenditures, and complex and costly scientific and technological advances.
Through its Open Innovation strategy, Sanofi seeks to improve efficiency in the R&D phase of drug development, not only in basic research and drug discovery, but also by introducing translational medicine, which links basic research to clinical and product use, and by effectively validating the efficacy of therapeutics at the earliest stages of drug development.
Global R&D
Pursuing innovations that save lives

Contributing to the revitalisation of the Korean pharma-bio industry and R&D ecosystem
In 2014 and 2017, Sanofi was certified as an Innovative Pharmaceutical Company by the Ministry of Health and Welfare in recognition of its ongoing efforts to contribute to the revitalisation of the Korean pharma-bio industry and R&D ecosystem.
- 23 joint research projects with local biotechs, universities, research institutes and hospitals.
- Inclusion of five Korean clinical trial centres, the first in Asia, in Sanofi's Premier Network, a network of outstanding clinical trial sites.
- Expanding partnerships with local pharmaceutical companies
Open Innovation in Korea
Driving open innovation with an open mind
Open innovation is a strategy to improve R&D efficiency through collaborative research and development with various partners, such as external academia, government, and industry, rather than closed R&D, where all research and development is conducted within a company. It is becoming an essential survival strategy for pharmaceutical companies in the face of declining R&D productivity, increasing socioeconomic burden on healthcare expenditures, and complex and costly scientific and technological advances.
Through its Open Innovation strategy, Sanofi seeks to improve efficiency in the R&D phase of drug development, not only in basic research and drug discovery, but also by introducing translational medicine, which links basic research to clinical and product use, and by effectively validating the efficacy of therapeutics at the earliest stages of drug development.

Contributing to the revitalisation of the Korean pharma-bio industry and R&D ecosystem
In 2014 and 2017, Sanofi was certified as an Innovative Pharmaceutical Company by the Ministry of Health and Welfare in recognition of its ongoing efforts to contribute to the revitalisation of the Korean pharma-bio industry and R&D ecosystem.
- 23 joint research projects with local biotechs, universities, research institutes and hospitals.
- Inclusion of five Korean clinical trial centres, the first in Asia, in Sanofi's Premier Network, a network of outstanding clinical trial sites.
- Expanding partnerships with local pharmaceutical companies
Expanded opportunities for global clinical participation
-
Established "Site Partnership," the first comprehensive new drug clinical research collaboration in Korea in 2012 (5 hospitals). Hospitals with advanced clinical infrastructure and excellent performance in at least three therapeutic areas are designated as partner sites and given priority participation opportunities in global clinical trials.
- In 2014, we signed a collaborative research agreement with Asan Medical Center in Seoul to analyze the genomes of liver cancer patients.
- Signed an MOU with Seoul National University Bundang Hospital in 2018 for a site partnership (totaling five hospitals)
Open Innovation Strategy to Create Synergies in R&D Research
-
Signed 26 joint research agreements with domestic bio ventures and research institutes by 2019
Partnerships with Domestic Companies
- Signed a long-term agreement with SK chemicals to jointly develop a pneumococcal protein conjugate vaccine (Sanofi Pasteur)
- Signed an agreement with Ulsan National Institute of Science and Technology to jointly research and develop targeted anti-cancer drugs
Cooperation with the Ministry of Health and Welfare to foster the domestic pharmaceutical industry
2009 - 2013 Signed an MOU worth KRW 70 billion to strengthen the competitiveness of domestic pharmaceutical research and development and achieved an investment plan in 2018 Signed an MOU with Seoul National University Hospital to attract early clinical trials in Korea